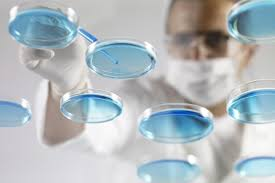

Science Researcher Update: Spotlight on Meetings, Conferences, and Events
Tags: 2013, USA, scientific research, Medicine, Symposium, December, Biomarkers, Alzheimer's Research, Indianapolis, IN, Alzheimer's, Life Sciences
Tags: 2014, CA, scientific research, US, Summit, February, San Diego, Life Sciences, Conference, Biotechnology, biotech
Tags: 2013, November, scientific research, United Kingdom, Research Meeting UK, Newport Pagnell, Conference, research scientists
Tags: 2013, current technology event, science current events, November, scientific research, United States, Development, King of Prussia, Engineering, Life Sciences, PA
Tags: 2013, Immunology, Biochemistry, scientific research, Symposium, Chemistry, October, Life Sciences, Drug Development
Tags: 2013, scientific research, Congress, Educational Event, September, germany, Frankfurt, Research
Conference - San Diego, CA, United States
Over the years, GTC’s Cytokines & Inflammation Conference has become an established meeting point for academic scientists, industry clinical developers, and government researchers to discuss complementary approaches in the field of cytokine biology.
Tags: 2014, CA, Biotech Event, Biochemistry, scientific research, US, January, San Diego, Life Sciences, Conference
Tags: 2013, science current events, scientific research, Medicine, September, Healthcare, Australia, Melbourne, Endocrinology, Life Sciences, Conference, Science Meetings